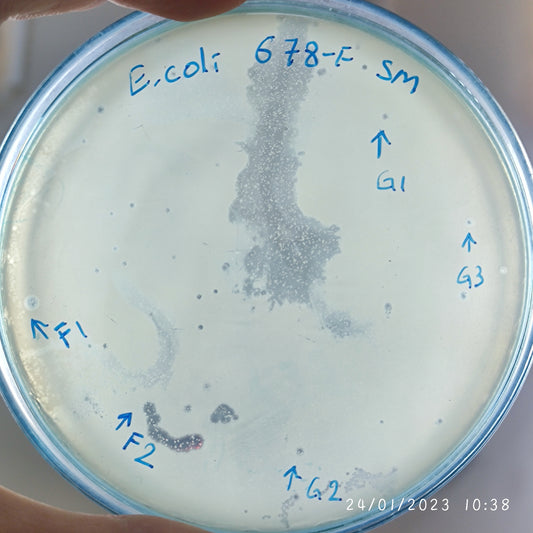
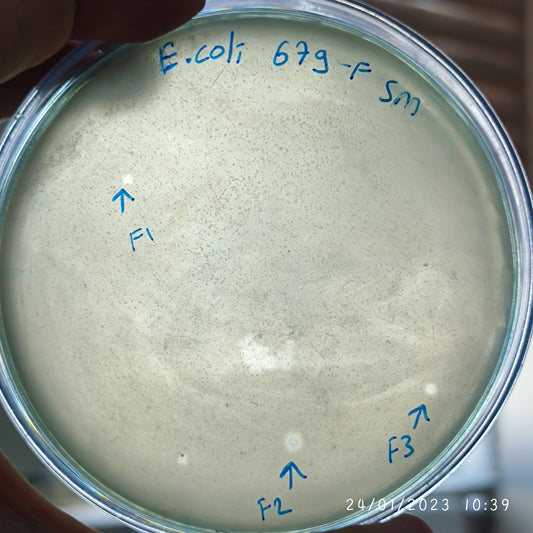
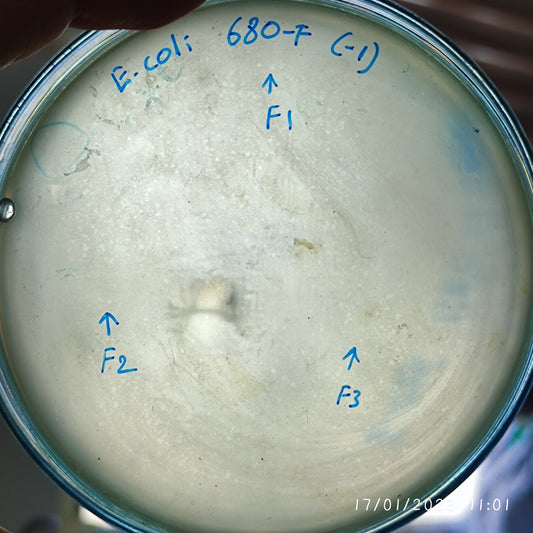
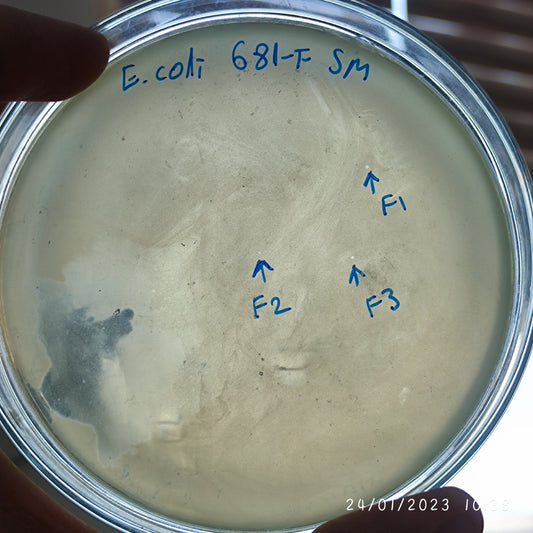
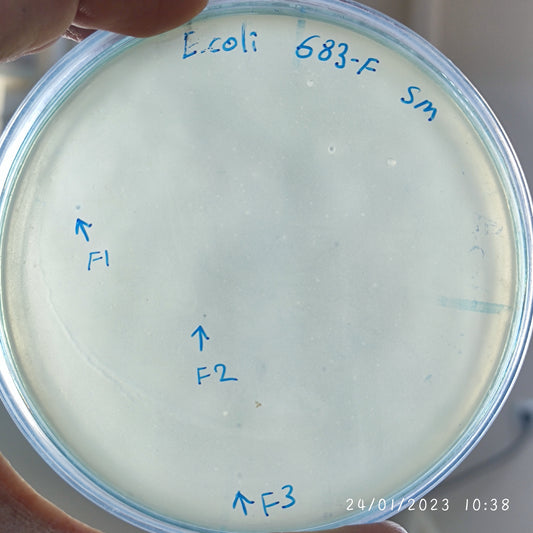
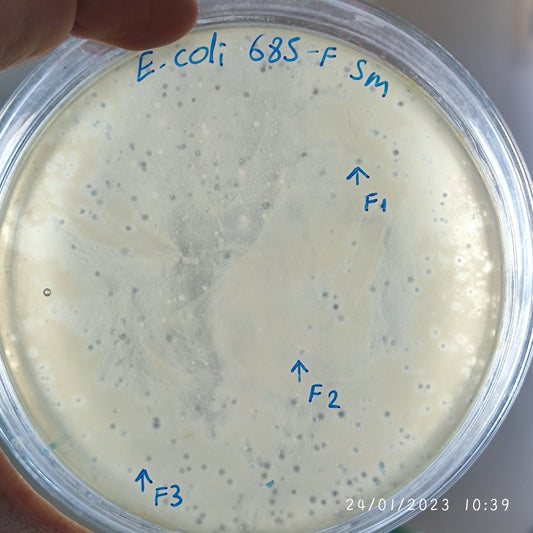
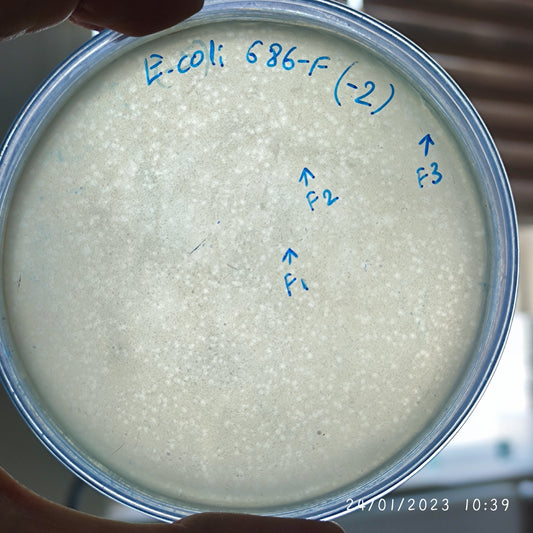
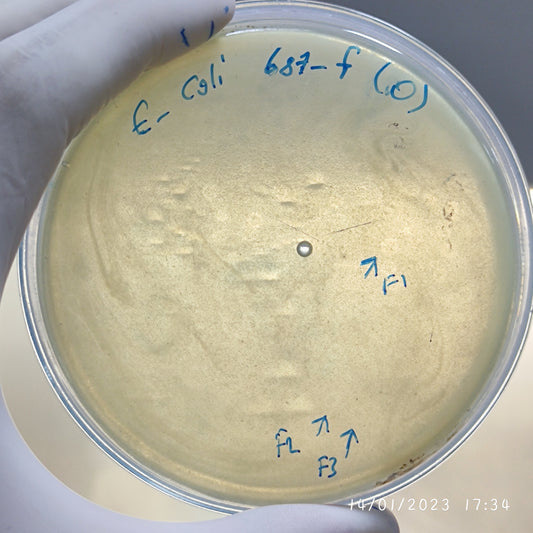
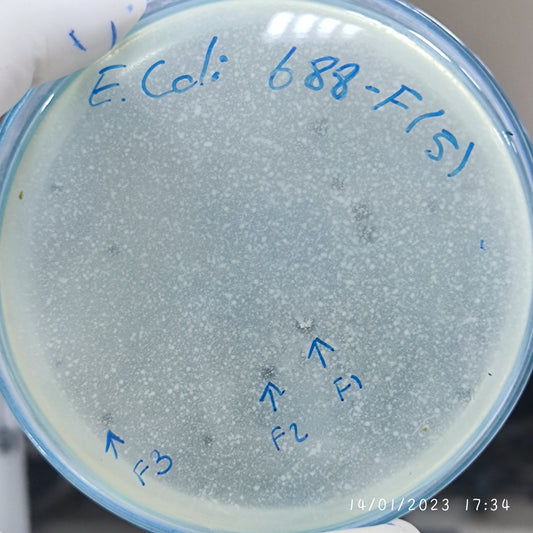
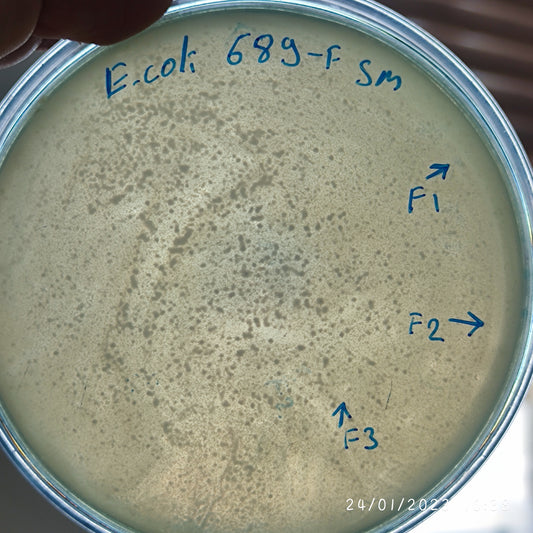
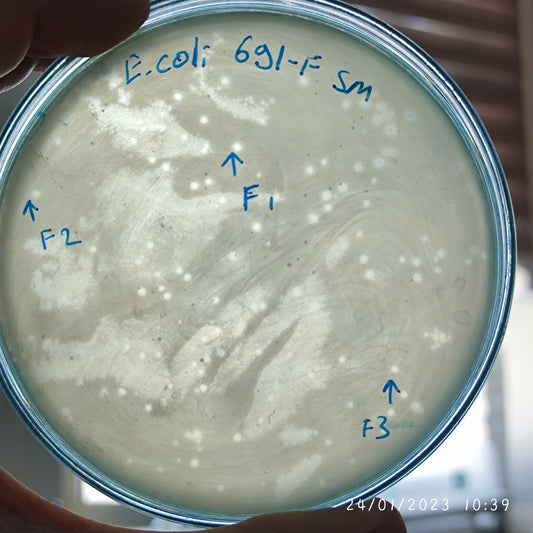
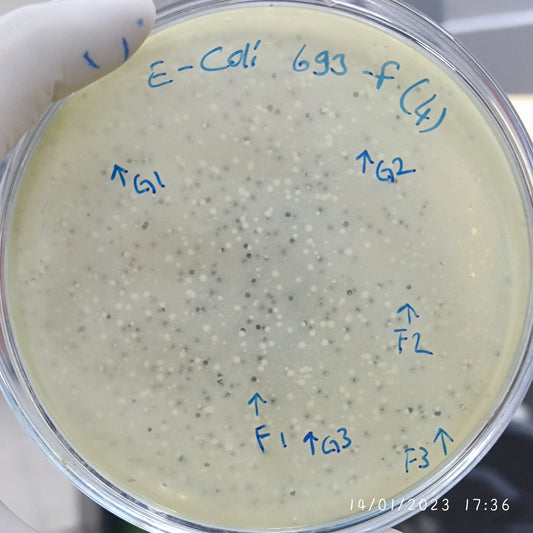
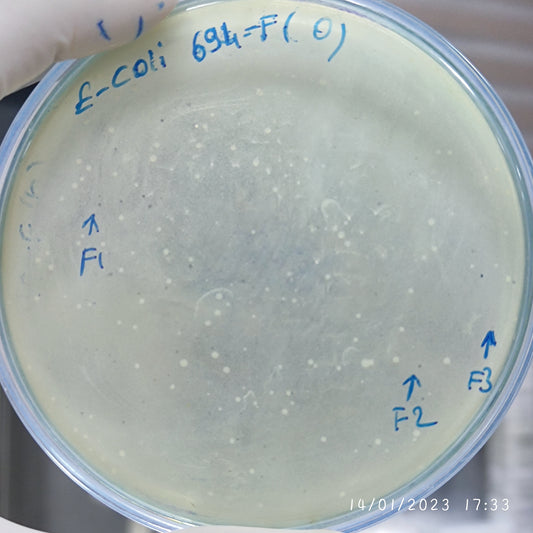

-
Escherichia coli bacteriophage 100678G
Regular price $750.00 USDRegular priceUnit price per -
Escherichia coli bacteriophage 100679F
Regular price $800.00 USDRegular priceUnit price per -
Escherichia coli bacteriophage 100680F
Regular price $500.00 USDRegular priceUnit price per -
Escherichia coli bacteriophage 100681F
Regular price $800.00 USDRegular priceUnit price per -
Escherichia coli bacteriophage 100683F
Regular price $750.00 USDRegular priceUnit price per -
Escherichia coli bacteriophage 100684F
Regular price $700.00 USDRegular priceUnit price per -
Escherichia coli bacteriophage 100685F
Regular price $800.00 USDRegular priceUnit price per -
Escherichia coli bacteriophage 100686F
Regular price $500.00 USDRegular priceUnit price per -
Escherichia coli bacteriophage 100687F
Regular price $400.00 USDRegular priceUnit price per -
Escherichia coli bacteriophage 100687G
Regular price $750.00 USDRegular priceUnit price per -
Escherichia coli bacteriophage 100688F
Regular price $500.00 USDRegular priceUnit price per -
Escherichia coli bacteriophage 100689F
Regular price $400.00 USDRegular priceUnit price per -
Escherichia coli bacteriophage 100691F
Regular price $800.00 USDRegular priceUnit price per -
Escherichia coli bacteriophage 100693F
Regular price $500.00 USDRegular priceUnit price per -
Escherichia coli bacteriophage 100693G
Regular price $500.00 USDRegular priceUnit price per -
Escherichia coli bacteriophage 100694F
Regular price $500.00 USDRegular priceUnit price per